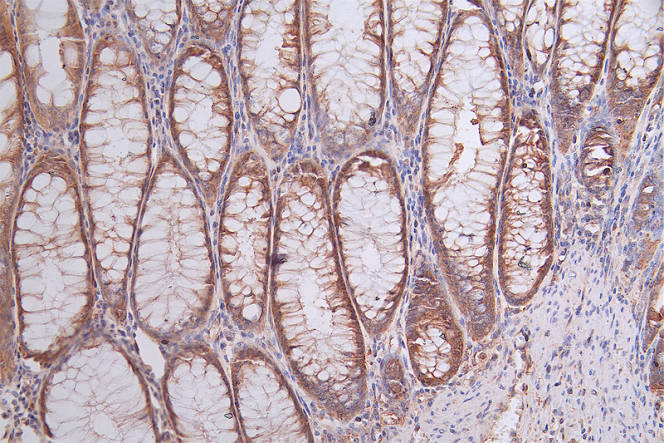
CSB-RA644510A0HU

HSP90AB1
HSP90AB1,即熱休克蛋白90α家族B類成員1,別名HSP84、HSPC2、HSPCB、D6S182、HSP90B等。HSP90AB1由人類HSP90AB1基因編碼,該基因位于6號(hào)染色體的p21.1區(qū)域。HSP90AB1是一種分子伴侶蛋白,屬于熱休克蛋白90家族,參與信號(hào)轉(zhuǎn)導(dǎo)、蛋白質(zhì)折疊和降解以及形態(tài)進(jìn)化。HSP90AB1在細(xì)胞內(nèi)與多種蛋白質(zhì)相互作用,影響多個(gè)生物學(xué)過程,包括對(duì)載肽的MHC1復(fù)合體在精子細(xì)胞中的成熟、hERG離子通道成熟過程中的處理以及對(duì)KCNQ4通道的生物生成和內(nèi)皮一氧化氮合酶(eNOS)活性的調(diào)控。此外,HSP90AB1還參與分泌型外泌體的釋放,促進(jìn)傷口愈合和炎癥反應(yīng)。在癌癥中,這些功能可被癌細(xì)胞利用,從而促進(jìn)其侵襲和轉(zhuǎn)移。HSP90AB1的高表達(dá)與多種癌癥類型的不良預(yù)后顯著相關(guān),使其成為癌癥治療的一個(gè)重要靶點(diǎn)。
熱銷產(chǎn)品
Recombinant Human Heat shock protein HSP 90-beta (HSP90AB1) (CSB-EP010808HU)
驗(yàn)證數(shù)據(jù)

(Tris-Glycine gel) Discontinuous SDS-PAGE (reduced) with 5% enrichment gel and 15% separation gel.

Based on the SEQUEST from database of E.coli host and target protein, the LC-MS/MS Analysis result of CSB-EP010808HU could indicate that this peptide derived from E.coli-expressed Homo sapiens (Human) HSP90AB1.

Based on the SEQUEST from database of E.coli host and target protein, the LC-MS/MS Analysis result of CSB-EP010808HU could indicate that this peptide derived from E.coli-expressed Homo sapiens (Human) HSP90AB1.
HSP90AB1 Recombinant Monoclonal Antibody (CSB-RA644510A0HU)
驗(yàn)證數(shù)據(jù)

IHC image of CSB-RA644510A0HU diluted at 1:50 and staining in paraffin-embedded human testis tissue performed on a Leica BondTM system. After dewaxing and hydration, antigen retrieval was mediated by high pressure in a citrate buffer (pH 6.0). Section was blocked with 10% normal goat serum 30min at RT. Then primary antibody (1% BSA) was incubated at 4°C overnight. The primary is detected by a Goat anti-rabbit polymer IgG labeled by HRP and visualized using 0.74% DAB.
IHC image of CSB-RA644510A0HU diluted at 1:50 and staining in paraffin-embedded human rectal cancer performed on a Leica BondTM system. After dewaxing and hydration, antigen retrieval was mediated by high pressure in a citrate buffer (pH 6.0). Section was blocked with 10% normal goat serum 30min at RT. Then primary antibody (1% BSA) was incubated at 4°C overnight. The primary is detected by a Goat anti-rabbit polymer IgG labeled by HRP and visualized using 0.74% DAB.

Overlay Peak curve showing Hela cells stained with CSB-RA644510A0HU (red line) at 1:50. The cells were fixed in 4% formaldehyde and permeated by 0.2% TritonX-100. Then 10% normal goat serum to block non-specific protein-protein interactions followed by the antibody (1μg/1*106cells) for 45min at 4℃. The secondary antibody used was FITC-conjugated Goat Anti-rabbit IgG(H+L) at 1:200 dilution for 35min at 4℃.Control antibody (green line) was rabbit IgG (1μg/1*106cells) used under the same conditions. Acquisition of >10,000 events was performed.
Human Heat shock protein HSP 90-beta(HSP90AB1) ELISA kit (CSB-EL010808HU)
驗(yàn)證數(shù)據(jù)

貨號(hào):CSB-EL010808HU
規(guī)格:96T/48T
靈敏度:0.39 ng/mL
檢測(cè)范圍:1.56 ng/mL-100 ng/mL
These standard curves are provided for demonstration only. A standard curve should be generated for each set of samples assayed.
HSP90AB1 Antibodies
HSP90AB1 for Homo sapiens (Human)
| 產(chǎn)品貨號(hào) | 產(chǎn)品名稱 | 種屬反應(yīng)性 | 應(yīng)用類型 |
|---|---|---|---|
| CSB-PA010808GA01HU | HSP90AB1 Antibody | Human,Mouse,Rat | ELISA,WB,IHC |
| CSB-PA060032 | Phospho-HSP90AB1 (Ser254) Antibody | Human,Mouse,Rat | ELISA,WB |
| CSB-PA208450 | HSP90AB1 (Ab-254) Antibody | Human,Mouse,Rat | ELISA,WB,IHC,IF |
| CSB-PA575867 | HSP90AB1 (Ab-254) Antibody | Human,Mouse,Rat | ELISA,WB,IHC,IF |
| CSB-PA00109A0Rb | HSP90AB1 Antibody | Human | ELISA, WB, IHC, IF |
| CSB-PA00109D0Rb | HSP90AB1 Antibody, Biotin conjugated | Human | ELISA |
| CSB-PA000726 | Phospho-HSP90AB1 (S254) Antibody | Human, Mouse, Rat, Monkey | WB, IHC, IF, ELISA |
| CSB-PA002980 | HSP90AB1 Antibody | Human,Mouse,Rat,Monkey | WB, IHC, IP, IF, ELISA |
| CSB-PA009327 | Phospho-HSP90AB1 (S226) Antibody | Human,Mouse,Rat | WB, IHC, IF, ELISA |
| CSB-PA009330 | HSP90AB1 Antibody | Human,Mouse,Rat | WB, IHC, IF, ELISA |
| CSB-RA904894A0HU | HSP90AB1 Recombinant Monoclonal Antibody | Human | ELISA, WB, IHC, IF, FC |
| CSB-RA644510A0HU | HSP90AB1 Recombinant Monoclonal Antibody | Human | ELISA, IHC, FC |
HSP90AB1 for H, M, R
| 產(chǎn)品貨號(hào) | 產(chǎn)品名稱 | 種屬反應(yīng)性 | 應(yīng)用類型 |
|---|---|---|---|
| CSB-MA000289 | HSP90AB1 Monoclonal Antibody | Human,Mouse,Rat | ELISA,WB |
HSP90AB1 Proteins
HSP90AB1 Proteins for Mus musculus (Mouse)
| 產(chǎn)品貨號(hào) | 產(chǎn)品名稱 | 來源 |
|---|---|---|
| CSB-YP010808MO CSB-EP010808MO CSB-EP010808MO-B |
Recombinant Mouse Heat shock protein HSP 90-beta (Hsp90ab1) | Yeast E.coli In Vivo Biotinylation in E.coli |
HSP90AB1 Proteins for Oryctolagus cuniculus (Rabbit)
| 產(chǎn)品貨號(hào) | 產(chǎn)品名稱 | 來源 |
|---|---|---|
| CSB-YP010808RB CSB-EP010808RB CSB-BP010808RB CSB-MP010808RB CSB-EP010808RB-B |
Recombinant Rabbit Heat shock protein HSP 90-beta (HSP90AB1) | Yeast E.coli Baculovirus Mammalian cell In Vivo Biotinylation in E.coli |
HSP90AB1 Proteins for Homo sapiens (Human)
| 產(chǎn)品貨號(hào) | 產(chǎn)品名稱 | 來源 |
|---|---|---|
| CSB-YP010808HU CSB-MP010808HU CSB-EP010808HU-B |
Recombinant Human Heat shock protein HSP 90-beta (HSP90AB1) | Yeast Mammalian cell In Vivo Biotinylation in E.coli |
| CSB-EP010808HU | Recombinant Human Heat shock protein HSP 90-beta (HSP90AB1) | E.coli |
| CSB-BP010808HU | Recombinant Human Heat shock protein HSP 90-beta (HSP90AB1) | Baculovirus |
HSP90AB1 Proteins for Rattus norvegicus (Rat)
| 產(chǎn)品貨號(hào) | 產(chǎn)品名稱 | 來源 |
|---|---|---|
| CSB-YP010808RA CSB-EP010808RA CSB-BP010808RA CSB-MP010808RA CSB-EP010808RA-B |
Recombinant Rat Heat shock protein HSP 90-beta (Hsp90ab1) | Yeast E.coli Baculovirus Mammalian cell In Vivo Biotinylation in E.coli |
HSP90AB1 Proteins for Danio rerio (Zebrafish) (Brachydanio rerio)
| 產(chǎn)品貨號(hào) | 產(chǎn)品名稱 | 來源 |
|---|---|---|
| CSB-YP010808DIL CSB-EP010808DIL CSB-BP010808DIL CSB-MP010808DIL CSB-EP010808DIL-B |
Recombinant Danio rerio Heat shock protein HSP 90-beta (hsp90ab1), partial | Yeast E.coli Baculovirus Mammalian cell In Vivo Biotinylation in E.coli |
HSP90AB1 Proteins for Macaca fascicularis (Crab-eating macaque) (Cynomolgus monkey)
| 產(chǎn)品貨號(hào) | 產(chǎn)品名稱 | 來源 |
|---|---|---|
| CSB-YP686992MOV1 CSB-EP686992MOV1 CSB-BP686992MOV1 CSB-MP686992MOV1 CSB-EP686992MOV1-B |
Recombinant Macaca fascicularis Heat shock protein HSP 90-beta (Hsp90ab1), partial | Yeast E.coli Baculovirus Mammalian cell In Vivo Biotinylation in E.coli |
HSP90AB1 Proteins for Pongo abelii (Sumatran orangutan)
| 產(chǎn)品貨號(hào) | 產(chǎn)品名稱 | 來源 |
|---|---|---|
| CSB-YP722308PYX CSB-EP722308PYX CSB-BP722308PYX CSB-MP722308PYX CSB-EP722308PYX-B |
Recombinant Pongo abelii Heat shock protein HSP 90-beta (HSP90AB1), partial | Yeast E.coli Baculovirus Mammalian cell In Vivo Biotinylation in E.coli |
HSP90AB1 Proteins for Bos taurus (Bovine)
| 產(chǎn)品貨號(hào) | 產(chǎn)品名稱 | 來源 |
|---|---|---|
| CSB-YP751863BO CSB-EP751863BO CSB-BP751863BO CSB-MP751863BO CSB-EP751863BO-B |
Recombinant Bovine Heat shock protein HSP 90-beta (HSP90AB1), partial | Yeast E.coli Baculovirus Mammalian cell In Vivo Biotinylation in E.coli |
HSP90AB1 Proteins for Equus caballus (Horse)
| 產(chǎn)品貨號(hào) | 產(chǎn)品名稱 | 來源 |
|---|---|---|
| CSB-YP872383HO CSB-EP872383HO CSB-BP872383HO CSB-MP872383HO CSB-EP872383HO-B |
Recombinant Horse Heat shock protein HSP 90-beta (HSP90AB1), partial | Yeast E.coli Baculovirus Mammalian cell In Vivo Biotinylation in E.coli |
HSP90AB1 ELISA Kit
HSP90AB1 ELISA Kit for Homo sapiens (Human)
| 產(chǎn)品貨號(hào) | 產(chǎn)品名稱 | 樣本類型 | 靈敏度 |
|---|---|---|---|
| CSB-EL010808HU | Human Heat shock protein HSP 90-beta(HSP90AB1) ELISA kit | serum, plasma, tissue homogenates | 0.39 ng/mL |
HSP90AB1 ELISA Kit for Mus musculus (Mouse)
| 產(chǎn)品貨號(hào) | 產(chǎn)品名稱 | 樣本類型 | 靈敏度 |
|---|---|---|---|
| CSB-EL010808MO | Mouse Heat shock protein HSP 90-beta(HSP90AB1) ELISA kit | serum, plasma, tissue homogenates, cell lysates | 3.9 pg/mL |














